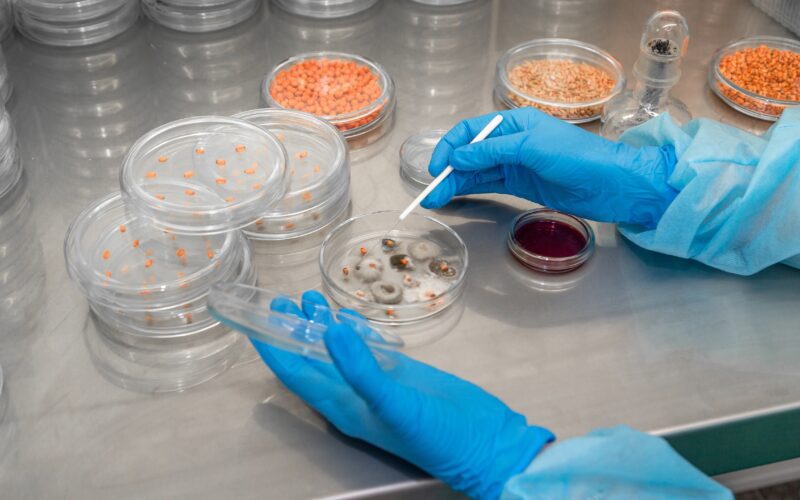

The Health Care Select Sector SPDR Fund (NYSE:XLV) is one of the most widely recognized exchange-traded funds providing targeted exposure to the healthcare sector within the S&P 500. Launched in 1998 and managed by State Street Global Advisors, XLV was designed to track the Health Care Select Sector Index, which includes some of the largest and most influential healthcare companies in the United States. It offers investors access to a diversified basket of pharmaceutical giants, biotechnology innovators, healthcare providers, life sciences firms, and medical equipment leaders, making it a go-to vehicle for those seeking broad exposure to the industry in a single investment.
Over the years, XLV has established itself as a cornerstone fund for institutional and retail investors alike due to its stability, liquidity, and cost-efficiency. Its portfolio typically covers major industry leaders such as Johnson & Johnson, UnitedHealth Group, Pfizer, Eli Lilly, Merck, and Abbott Laboratories, among others. This concentration in global healthcare powerhouses allows XLV to capture the steady growth of established firms while also participating in the high-upside potential of biotech breakthroughs and medical innovations. The fund’s market-cap weighted structure ensures that investors’ capital follows the performance of the sector’s biggest drivers, balancing defensive resilience with growth opportunities.
The healthcare sector itself is a vital pillar of the U.S. economy, accounting for trillions in annual spending and supported by structural tailwinds such as an aging population, rising life expectancies, and growing demand for advanced treatments. XLV has been able to reflect this growth trajectory over decades, making it a reliable option for long-term investors seeking both defensive protection during economic downturns and consistent participation in innovation-driven upswings. Its low expense ratio and deep liquidity further add to its appeal, solidifying its place as one of the most efficient vehicles for healthcare investing in global markets.
The Health Care Select Sector SPDR Fund Gains Momentum Amid Sector Shakeups
The Health Care Select Sector SPDR Fund (NYSEARCA: XLV) is once again at the center of investor attention, benefiting from both structural tailwinds in the healthcare sector and short-term catalysts that have pushed the industry higher. This week alone has underscored the resilience and dynamism of the healthcare sector, as major biotechnology acquisitions, leadership changes at global pharmaceutical giants, and pivotal trial results shifted the narrative for investors. Sector ETFs, including XLV, have been on the rise, reaffirming the importance of healthcare as both a defensive allocation and a growth play in modern portfolios.

CHECK THIS OUT: Tiziana (TLSA) Surges 143% in 2025 and Immuneering (IMRX) Reports 86% 9-Month Survival in Pancreatic Cancer.
Biotech Dealmaking Heats Up and Fuels Investor Interest
One of the strongest bullish arguments for XLV comes from the ongoing wave of consolidation and strategic acquisitions in healthcare. This week, Genmab’s stunning $8 billion all-cash acquisition of Merus highlighted the growing appetite of cash-rich pharmaceutical companies to secure innovative pipelines. While the acquiring company saw some near-term pressure, the broader signal was clear: biotech innovation remains highly sought-after, and capital is flowing aggressively into promising therapies.
For XLV investors, this type of dealmaking is a reminder of the growth upside embedded within the sector. Consolidation validates valuations, strengthens competitive positioning, and often accelerates timelines to bring therapies to market. As these trends intensify, ETFs like XLV benefit directly from broad-based sector momentum, capturing gains from both the acquiring companies and their targets.
Clinical Trial Volatility Highlights Risks but Fuels Opportunity
Healthcare investing is known for its volatility, and this week provided a vivid example when MoonLake Immunotherapeutics saw its shares collapse by over 87% after rival UCB delivered stronger-than-expected trial results for a skin disease treatment. For investors in individual biotech stocks, this type of binary event can be catastrophic. But for XLV investors, the diversified structure of the ETF provides insulation while still capturing the upside of sector-wide breakthroughs.
The lesson here is clear: clinical outcomes may shift fortunes for specific names, but the healthcare sector as a whole continues to advance. By holding XLV, investors participate in the broader wave of innovation while mitigating the company-specific risks that can devastate smaller-cap biotech portfolios. This risk-reward balance is a key bullish point for allocating to XLV rather than concentrating exposure in single, high-volatility biotech stocks.
Leadership Changes and Strategic Shifts Support Long-Term Growth
Another catalyst this week came from GSK, which announced a key leadership change that immediately boosted investor confidence, lifting shares by more than 2% in pre-market trading. Leadership transitions are critical in the pharmaceutical and biotech space, where strategic vision and execution determine success in bringing new therapies to market. For large-cap constituents of XLV, investor sentiment often hinges on whether management teams can adapt to shifting regulatory, competitive, and scientific landscapes.
This example illustrates how XLV provides exposure to companies that are constantly recalibrating for growth. The healthcare sector is not static; it evolves quickly through leadership moves, pipeline prioritization, and partnerships. With global health care spending projected to surpass $10 trillion this year, leadership decisions that unlock growth potential become catalysts that can move entire subsectors—and XLV captures those moves across its holdings.
ETF Gains Reflect Broader Market Confidence in Healthcare
The combination of biotech dealmaking, clinical milestones, and management transitions has fueled renewed investor optimism in healthcare ETFs. XLV has been a direct beneficiary, gaining momentum as capital rotates into the sector. The ETF’s diversified exposure across pharmaceuticals, biotechnology, healthcare providers, and medical devices provides broad coverage of the trends that are currently shaping the industry.
This week’s events reflect a larger pattern: investors are positioning in healthcare as a defensive growth sector. With consolidation activity already topping $100 billion this year, according to Refinitiv data, and surpassing 2023 totals, momentum in dealmaking alone offers a strong growth signal. Add to that the sector’s defensive appeal during market volatility, and XLV stands out as a vehicle capable of delivering both stability and upside.
The Bigger Picture: Innovation and Demographics Create Durable Demand
While short-term catalysts have provided the spark, the bullish thesis for XLV rests on long-term fundamentals. Healthcare is underpinned by aging demographics, rising prevalence of chronic diseases, and an unrelenting pace of innovation in biotechnology and medical technology. From gene therapies and precision medicine to robotic surgery and artificial intelligence-driven diagnostics, the sector is undergoing transformational change.
Healthcare demand is largely inelastic, meaning it persists regardless of economic cycles. This makes XLV a resilient allocation in times of uncertainty, while innovation creates opportunities for growth that can outpace the broader market. As global health care spending climbs into the double-digit trillions, the companies within XLV are well positioned to capture that growth.
Conclusion: XLV as a Core Healthcare Growth and Defense Play
The Health Care Select Sector SPDR Fund offers investors the best of both worlds: exposure to defensive, cash-generating giants and access to the high-growth potential of biotechnology and medical innovation. This week’s developments—ranging from an $8 billion biotech acquisition to leadership changes at major pharmaceutical firms—illustrate the dynamism of the sector and its capacity to surprise investors on both the upside and downside. By holding XLV, investors gain diversified exposure to these forces without overexposing themselves to the binary risks of individual stocks.
With consolidation accelerating, clinical innovation reshaping the competitive landscape, and demographic trends fueling durable demand, XLV remains a compelling bullish play for those seeking both stability and growth in their portfolios.
READ ALSO: CEL-SCI (CVM) Stock Could Explode After Saudi Breakthrough Deal and Ondas Holdings (ONDS) Lands $2.7M Defense Order.